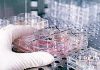
Cara ministro Roccella, i figli della fecondazione eterologa sono tanti in Italia

(Adnkronos) – Il presidente degli Stati Uniti Joe Biden ha voluto rivolgere, con un tweet, i suoi auguri ai fedeli musulmani in occasione dell’inizio del Ramadan. ”Stasera – mentre la nuova falce di luna segna l’inizio del mese sacro islamico del Ramadan – Jill e io estendiamo i nostri migliori auguri e preghiere ai musulmani in tutto il nostro Paese e in tutto il mondo”, ha scritto Biden.
In una nota della Casa Bianca si sottolinea che il Ramadan rappresenta ”un momento di riflessione e di rinnovamento. Quest’anno arriva in un momento di immenso dolore”. Biden ha ricordato che ”la guerra a Gaza ha inflitto una terribile sofferenza al popolo palestinese” e spiegato che ”oltre 30mila palestinesi sono stati uccisi, in gran parte civili, tra cui miglia di bambini”. Inoltre, ha continuato Biden, ”circa due milioni di palestinesi sono stati sfollati a causa della guerra”.
In questo mese sacro all’Islam ”la sofferenza del popolo palestinese sarà il primo pensiero di molti. Sarà il mio primo pensiero” ha affermato l’inquilino della Casa Bianca. ”Gli Stati Uniti continueranno a guidare gli sforzi internazionali per portare più assistenza umanitaria a Gaza via terra, via aria e via mare”, sottolineando l’avvio di ”una missione di emergenza” e ”il lancio di aiuti in collaborazione insieme ai nostri alleati internazionali, compresa la Giordania”.
L’Amministrazione americana guidata da Biden ritiene che l’operazione militare israeliana su Rafah, nel sud della Striscia di Gaza, non sia imminente e non avrà luogo nel prossimo futuro. Lo riferiscono due funzionari americani alla Cnn.
Nelle scorse ore il primo ministro israeliano Benjamin Netanyahu aveva detto che porterà avanti un’offensiva militare a Rafah, dove si rifugiano 1,5 milioni di palestinesi sfollati, nonostante Biden abbia riferito che questa operazione rappresenterebbe una “linea rossa”.